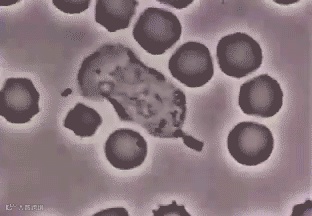
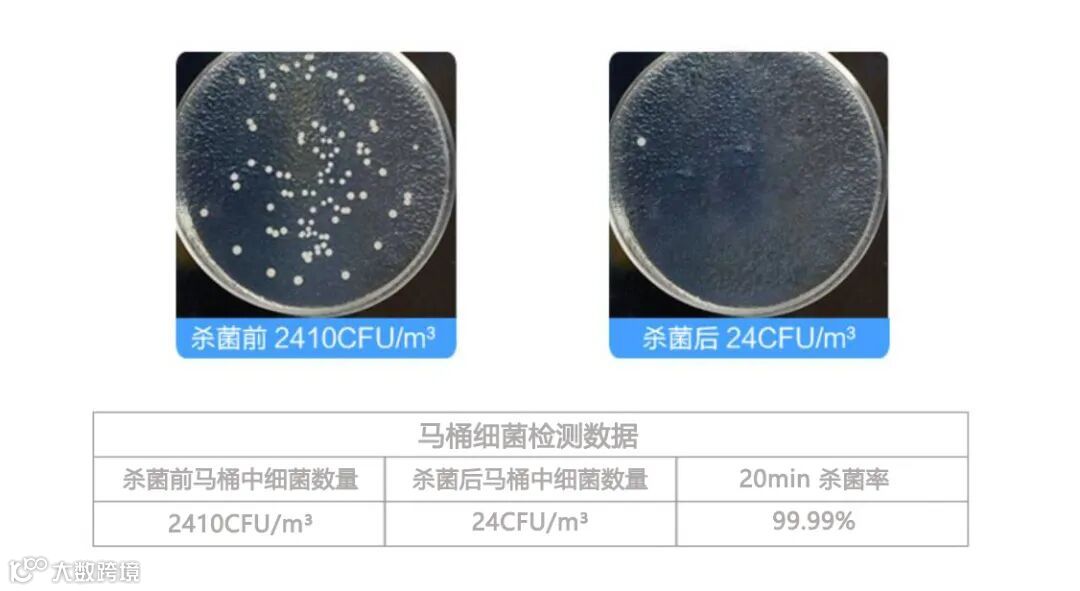

大家有没有发现:一提到细菌多又脏的东西,很多人首先想到的就是与马桶比较。
空调不清洗比马桶还脏、用错牙膏口腔比马桶还脏、首饰佩戴品不洗比马桶还脏……
但马桶本身有多脏,却往往被人忽视。为了一探究竟,我们收集了大量资料发现:
据美国耶鲁大学实验室曾证实,每只马桶上至少存在18W个微生物,有些甚至能存活长达17天之久!
其中包含我们常见的大肠杆菌、痢疾杆菌和金黄色葡萄球菌。一旦抵抗力差的人遇上,便很有可能引发腹泻、发热、呕吐等急性症状。

据世界卫生组织数据显示:2019年因与马桶直接接触而感染症状的有190万人,其中感染高发人群为3-7岁儿童,占比24%!
想起家里的小孩某次莫名其妙的生病,不由得细思极恐。

这样的“脏”马桶,你还坐得下去吗?细菌病毒看不见也冲不走,还危害身体健康!
但以往常用的洁厕液、浴室清洁剂等马桶消毒产品,不是味道刺激,就是清洁不干净,连臭味都没去掉!
还有那种消毒球,往马桶水里边加化学物质,不安全;而且隔一两个月要换一次,不实用。

为此LUNSH团队为研究消灭马桶上的细菌,大胆提出一个构想.:能把餐具的消毒方式,应用到马桶吗?
经过多次开模设计,做了上千次实验,Lunsh马桶消毒器终于以手机一半大小的形态问世了!
它自带纳米紫外线杀菌灯,只需随手一盖,杀菌率高达99.99%!充电一次,续航40天、无需复购,使用20年以上,性价比无敌!
不同于以往手持式的,每一次如厕前都要亲自手动消毒,即麻烦又不方便。
整个过程无需人工干预,既安全又便捷。(完毕后会自动关闭)
紫外线作为“天然的杀菌剂”,常年应用在很多医疗、工业场所,对常见细菌和病毒都有杀灭作用。
而相关数据显示,只有波长在240-280纳米的C段紫外线才具有强劲的杀菌消毒功能。
基于此,Lunsh不惜下重金为这款马桶消毒器搭载了高配UV石英灯管,使它能发出波长为253.7nm的紫外线。(这段波长的紫外线杀菌作用最强)
紫外线透射率高达90%,可以强力破坏细菌病毒中的DNA或RNA分子结构,造成细胞失活,达到杀菌消毒的效果。
同时空气中氧气在紫外线特定波段照射下,会分解成臭氧。
臭氧能协助紫外线,氧化破坏其余残留的细胞内酶,致死病原体,让细菌病毒无处可逃!
用它杀菌除味以后,马桶就像被雨洗过一样,能闻到清新的味道!
有了Lunsh马桶消毒器,从此就可以和细菌、病毒、异味说再见了。
再也不担心马桶细菌污染皮肤,有效预防各种疾病产生,让一家人上厕所变得更加健康、安全。
Lunsh马桶消毒器
符合CE认证
,质量可靠,用着放心。
灯管选用了
在
军工、半导体、通信
等领域广泛应用的
石英材质
,硬度高,还绝缘耐腐蚀。
内置
1200mAh大容量电池
,续航超长,
1次充满电后
可使用长达40天!
(按照每周2次,每次5分钟的使用频率)
没电也不怕,
USB快充
,很快就能“满电复活”。
背面3M进口胶,越粘越紧的特性不会让消毒器轻易脱落。
经测试,无论怎么开合,它都能稳稳地粘着马桶盖,不用担心掉落的问题。
杀毒过程中,打开马桶盖超过30度,自动暂时关闭,确保不会误触。
使用过后,机器主体也可以直接拿出来,方便下次使用。
它不仅能用于马桶,还可以
备多一件家居杀菌使用
。
如果说家里能和马桶“脏”相提并论的,当属
垃圾桶
了。
每天接纳各种各样的废弃物,稍不留神就会变成一个
藏污纳垢的“细菌窝”
!因此用它来给垃圾桶也非常有必要。
还可以给
衣柜、鞋柜、冰箱、玩具柜
等绝大部分地方/物品消消毒,杀灭潜在的细菌。在家这样防护,才够安心。
1
.这是消毒器,可以用来消毒杀菌除异味,但不能清洁除渍。
2.
使用过程中,请远离消毒器的工作空间,切勿将设备与眼睛和皮肤接触。
3.
使用产品后,会有较淡的臭氧味,及时通风或静待10分钟后即可自行消散(这个过程同样有杀菌除味的作用)。
4.
杀菌完成后建议把机器拆下,避免儿童老人误触开关,造成不必要的伤
害。
现在通过此下单,
原价218元,直降100元,只需118元
!
!!
而且这款马桶消毒器使用寿命长达10000小时,
平均下来每天不到3毛钱
就能让马桶保持干净无菌,省去亲自刷洗的烦恼
,实在太划算了!